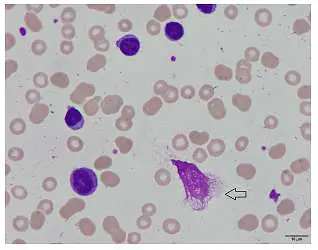
圖片描述
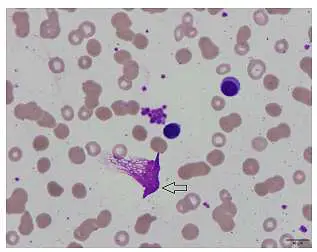
圖片描述

113年:(醫檢)血液(1)
有關如圖箭號所指的細胞, 下列敘述何者錯誤

A常可見於 chronic lymphocytic leukemia
B是 smudge cells
C是 basket cells
D是由於細胞骨架蛋白質vimentin 含量異常增加所致
詳細解析
本題觀念:
本題考察慢性淋巴性白血病(CLL)血液塗片上所見的碎裂細胞(smudge cells/basket cells)之形成機制、命名與臨床意義。
影像分析:
從兩張周邊血塗片影像可見:
- 孤立或散在地分布著染成深紫色的片狀結構,無明顯細胞膜界限,僅殘存不規則的核染質或核絲樣結構。
- 其周圍血球(主要為紅血球)正常排列,但該細胞本體已崩解,未見典型細胞質或細胞膜。
- 形態如同「網籃」(basket)或「污漬」(smudge),屬於塗片製備過程中細胞破裂的偽影(artifact)。
上述特徵符合 CL L 患者外周血塗片中常見的 smudge cells(亦稱 basket cells)。
選項分析
-
選項A「常可見於 chronic lymphocytic leukemia」
文獻指出,幾乎所有 CLL 患者的血塗片皆可見 smudge cells,且百分比可達數十%,為該病的常見表現之一 (ascopubs.org)。此選項為正確敘述。 -
選項B「是 smudge cells」
影像所示即為 smudge cells(或稱 Gumprecht’s
...(解析預覽)...

升級 VIP 解鎖圖文解析